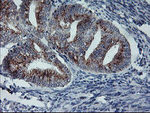
ARCN1 Antibody in Immunohistochemistry (Paraffin) (IHC (P))

Search
OriGene
ARCN1 Monoclonal Antibody (OTI6A6), TrueMAB™
{{$productOrderCtrl.translations['antibody.pdp.commerceCard.promotion.promotions']}}
{{$productOrderCtrl.translations['antibody.pdp.commerceCard.promotion.viewpromo']}}
{{$productOrderCtrl.translations['antibody.pdp.commerceCard.promotion.promocode']}}: {{promo.promoCode}} {{promo.promoTitle}} {{promo.promoDescription}}. {{$productOrderCtrl.translations['antibody.pdp.commerceCard.promotion.learnmore']}}
产品信息
TA504315
种属反应
宿主/亚型
分类
类型
克隆号
抗原
偶联物
形式
浓度
纯化类型
保存液
内含物
保存条件
运输条件
靶标信息
This gene maps in a region, which include the mixed lineage leukemia and Friend leukemia virus integration 1 genes, where multiple disease-associated chromosome translocations occur. It is an intracellular protein. Archain sequences are well conserved among eukaryotes and this protein may play a fundamental role in eukaryotic cell biology. It has similarities to heat shock proteins and clathrin-associated proteins, and may be involved in vesicle structure or trafficking.
仅用于科研。不用于诊断过程。未经明确授权不得转售。
篇参考文献 (0)
生物信息学
蛋白别名: Archain; archain vesicle transport protein 1; coatomer delta subunit; coatomer delta-COP; coatomer protein complex, subunit delta; coatomer protein delta-COP; Coatomer subunit delta; Delta-coat protein; Delta-COP; pale coat neuro
基因别名: 4632432M07Rik; ARCN1; COPD; nur17
UniProt ID: (Human) P48444, (Mouse) Q5XJY5, (Rat) Q66H80
Entrez Gene ID: (Dog) 479415, (Human) 372, (Mouse) 213827, (Rat) 300674